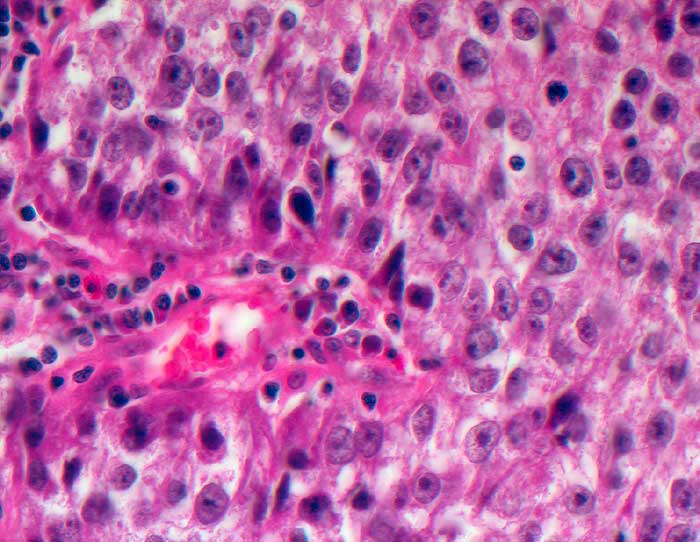

PathoPic – image database / PathoPic ID 5611 - Adenokarzinom der Prostata
de
Diagnose
Adenokarzinom der Prostata
Diagnose Gruppe
maligner Tumor
Topographie
Prostata
Topographie Gruppe
Genitalorgane, männlich
Beschreibung
Solide Tumormasse aus grossen polygonalen Tumorzellen mit auffallenden Nukleolen.
Bilder Typ
Histologie
Vergrösserung
400
Alter
67
Geschlecht
männlich
Datum
Ersteintrag: 26.12.2002
Update: 30.07.2010